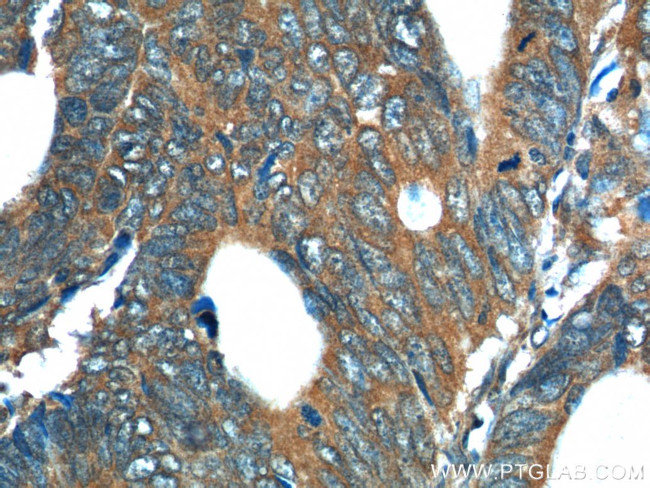
REG4 Antibody in Immunohistochemistry (Paraffin) (IHC (P))

Search
Proteintech
REG4 Polyclonal Antibody
{{$productOrderCtrl.translations['antibody.pdp.commerceCard.promotion.promotions']}}
{{$productOrderCtrl.translations['antibody.pdp.commerceCard.promotion.viewpromo']}}
{{$productOrderCtrl.translations['antibody.pdp.commerceCard.promotion.promocode']}}: {{promo.promoCode}} {{promo.promoTitle}} {{promo.promoDescription}}. {{$productOrderCtrl.translations['antibody.pdp.commerceCard.promotion.learnmore']}}
产品信息
12268-1-AP
种属反应
已发表种属
宿主/亚型
分类
类型
抗原
偶联物
形式
浓度
规格
纯化类型
保存液
内含物
保存条件
运输条件
产品详细信息
Immunogen sequence: VLGDIIMRP SCAPGWFYHK SNCYGYFRKL RNWSDAELEC QSYGNGAHLA SILSLKEAST IAEYISGYQR SQPIWIGLHD PQKRQQWQWI DGAMYLYRSW SGKSMGGNKH CAEMSSNNNF LTWSSNECNK RQHFLCKYRP (20-158 aa encoded by BC017089)
靶标信息
Reg IV is part of the regenerating gene family within the C-type lectin superfamily. This family is involved in liver, pancreatic, gastric and intestinal cell proliferation and differentiation. Reg IV is a 158-amino acid secretory protein implicated in cell regeneration and/or survival with a definite growth stimulating effect on pancreatic beta cells. It is highly expressed in colorectal, gastric, prostate and other types of cancer. Reg IV-positive tumor cells display different phenotypes including mucus-secreting, enterocyte-like, and undifferentiated.
仅用于科研。不用于诊断过程。未经明确授权不得转售。
生物信息学
蛋白别名: Gastrointestinal secretory protein; GISPREG-4; Reg IV; REG-4; REG-like protein; regenerating gene type IV; regenerating islet-derived family, member 4; Regenerating islet-derived protein 4; Regenerating islet-derived protein IV; RegIV; RELP; regenerating protein-like protein; alternatively spliced
基因别名: 2010002L15Rik; GISP; REG-IV; REG4; RELP
UniProt ID: (Human) Q8NER7, (Mouse) Q9D8G5, (Rat) Q68AX7
Entrez Gene ID: (Human) 83998, (Mouse) 67709, (Rat) 445583